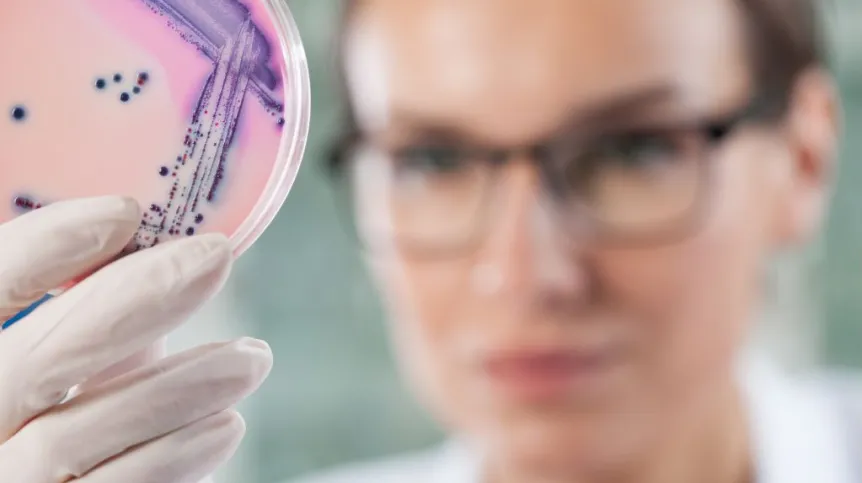

Fotografowie nauki i naukowcy, którzy efekty, przebieg lub okoliczności swojej pracy przedstawiają na zdjęciach, mogą podzielić się swoją twórczością i do końca listopada zgłosić się do konkursu Wiki Science Competition.
Na konkurs należy przesłać dowolną liczbę fotografii dokumentujących świat nauki: ukazujących obiekty i efekty badań, naukowców przy pracy czy aparaturę badawczą. Wyniki zostaną ogłoszone w styczniu 2018 r.
Poza nagrodami, dodatkową satysfakcją dla fotografów może być fakt, że wszystkie zdjęcia zgłoszone na konkurs będą dostępne są na tzw. wolnych licencjach lub w domenie publicznej. Będzie mógł z nich skorzystać zarówno autor hasła Wikipedii, twórca podręcznika akademickiego, wydawca prasowy, jak i producent koszulek. Bezpłatnie, bez warunków wstępnych. Dotychczas udostępnione fotografie ilustrują tysiące artykułów Wikipedii w wielu językach, a jednocześnie stanowią bezcenną bazę ilustracji naukowych dostępnych dla całego świata.
„Ciężko wyobrazić sobie naszą kulturę bez nauki. W obecnym świecie nie wystarczy mówić o nauce, musimy ją także pokazywać. Dlatego właśnie potrzebujemy fotografów, którzy zechcą ją fotografować i dzielić się efektami. Konkurs fotografii naukowej powstał, aby zachęcać do dzielenia się twórczością związaną z nauką” - mówi rzecznik Stowarzyszenia Wikimedia Polska Krzysztof Machocki. Ruch Wikimedia to społeczność stojąca za Wikipedią, wolną encyklopedią, oraz jej projektami siostrzanymi.
W tegorocznej edycji biorą udział już 23 sztaby lokalne, choć – jak w poprzednich latach – zdjęcia można nadsyłać niemal z całego świata. Już przeszło 850 naukowców z całego świata podzieliło się zdjęciami i grafikami przedstawiającymi efekty ich pracy - z Wikipedią i jej repozytorium zdjęć Wikimedia Commons.
Zdjęcia nadesłane z Polski lub przez polskich naukowców prowadzących badania za granicą zostaną ocenione przez jury. Autorzy najlepszych z nich otrzymają wikipedyjne upominki.
W skład jury wchodzą: belgijski rzeźbiarz i fotograf Dominique Stroobant, Elisa Araldi z Politechniki Federalnej w Zurychu, Andreas Brink ze Wspólnego Centrum Badawczego Komisji Europejskiej, Simon Duttwyler z Uniwersytetu Zhejiang, Gianni Ciofani z Politechniki w Turynie, Marcos Valdés z Scuola Normale Superiore di Pisa), Pille Säälik z Uniwersytetu w Tartu, Nuggehalli Srinivas Prashanth z Instytutu Zdrowia Publicznego w Bengaluru (Indie), Roderic D. M. Page z Glasgow University) oraz Xueqian Kong z Uniwersytetu Zhejiang.
Obrazy biorące udział w konkursie muszą zostać wykonane i przesłane do Wikimedia Commons przez samego autora, za pomocą konta w projektach Wikimedia. Podczas zakładania konieczne jest podanie adresu e-mail, by możliwe było skontaktowanie się ze zwycięzcami. W przypadku współautorstwa – konieczne jest podanie wszystkich współautorów. W przypadku instytucji obrazy powinien wgrać jej reprezentant. Wszystkie obrazy powinny zostać opatrzone opisem w języku angielskim oraz ewentualnie także w innych językach.
Aby przesłać pliki, wystarczy założyć konto lub zalogować się do jednego z projektów Wikimedia, na przykład do Wikipedii. Następnie należy wejść na stronę kreatora przesyłania i postępować zgodnie z instrukcją. Przesyłane obrazy powinny mieć minimum 2 megapiksele, chyba że technologia ich wykonania na to nie pozwala. Nie powinny zawierać niepotrzebnych znaków wodnych, logotypów, dodatkowych tekstów, grafik ani wstawek. Dopuszczalne są zdjęcia i grafiki udostępnione na jednej z wolnych licencji, lub w domenie publicznej (jeśli jest to legalnie możliwe w kraju przesyłającego). Dopuszczalne licencje to m.in. CC-BY-SA 4.0, CC-BY 4.0, CC0 1.0, i podobne.
IDEA PROMOCJI NAUKI I ROZPOWSZECHNIANIA JEJ DOROBKU
Jak tłumaczy Ivo Kruusamägi, biotechnolog z Uniwersytetu w Tartu i pomysłodawca konkursu, w WSC chodzi o ideę bardziej niż o nagrody. „Wikipedia to międzynarodowa platforma służąca dzieleniu się wiedzą. Byłoby grzechem, gdybyśmy nie wykorzystywali jej do promowania wartości, które mają dla nas tak wielkie znaczenie. Dlatego też informację o konkursie kierujemy przede wszystkim do uczelni, instytutów badawczych i samych naukowców” – mówi Kruusamägi. Jego zdaniem Wikipedia i jej projekty siostrzane wypełniają ważną lukę pomiędzy samą nauką, a jej promocją.
„Większości prac naukowych niemal nikt nie czyta. Z drugiej strony spektrum znajdują się prace czytane, cytowane przez portale poświęcone nauce, ale pisane językiem komunikatów prasowych, a więc zawierające bardzo niewiele informacji” – ocenia Kruusamägi. Jego zdaniem nie ma zbyt wielu źródeł, które stanowiłyby połączenie obu tych ekstremów. Takich, które dobrze i dogłębnie wyjaśniałyby jakiś temat, a jednocześnie służyłyby szerszej publiczności, były zrozumiałe i dostępne dla osób spoza wąskiego kręgu specjalistów z danej dziedziny.
„Takim źródłem wiedzy jest Wikipedia, medium, które świetnie nadaje się do tego, by wzmacniać głos naukowców i udostępniać go światu. Najłatwiej zacząć od zdjęć, ale naszym celem jest, by jak najwięcej informacji ze świata nauki trafiało także do Wikipedii” – wyjaśnia biotechnolog.
Nawet jedno zdjęcie może przydać się wikipedystom pracującym nad artykułami lub komuś spośród milionów użytkowników zdjęć zgromadzonych w repozytorium Wikimedia Commons. Wśród nich są także autorzy podręczników akademickich, studenci czy naukowcy z całego świata.
Konkurs organizowany jest raz na dwa lata, następna edycja planowana jest na koniec roku 2019.
Jego początki sięgają lat 2011-2013, kiedy w Estonii rozpoczęto organizację Estońskiego Konkursu Fotografii Naukowej. Pomysł zainspirował wikimedian z innych krajów, dlatego organizowany w 2015 roku Europejski Konkurs Fotografii Naukowej (European Science Photo Competition) objął już osiem państw europejskich (a zdjęcia nadesłano z 32 krajów, w tym kilkadziesiąt z Polski). W sumie w 2015 roku udało się w ten sposób pozyskać 9793 plików na wolnych licencjach od przeszło 2200 uczestników konkursu.
PAP – Nauka w Polsce
kol/ agt/
Fundacja PAP zezwala na bezpłatny przedruk artykułów z Serwisu Nauka w Polsce pod warunkiem mailowego poinformowania nas raz w miesiącu o fakcie korzystania z serwisu oraz podania źródła artykułu. W portalach i serwisach internetowych prosimy o zamieszczenie podlinkowanego adresu: Źródło: naukawpolsce.pl, a w czasopismach adnotacji: Źródło: Serwis Nauka w Polsce - naukawpolsce.pl. Powyższe zezwolenie nie dotyczy: informacji z kategorii "Świat" oraz wszelkich fotografii i materiałów wideo.